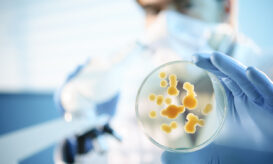

Μπορούν τα στενά ρούχα να προκαλέσουν προβλήματα στην υγεία μας; Τι να προσέχετε
Το να φοράτε πολύ στενά ρούχα μπορεί να οδηγήσει σε διάφορα προβλήματα υγείας, όπως πεπτικά προβλήματα, μυκητιάσεις και συμπίεση...

Το να φοράτε πολύ στενά ρούχα μπορεί να οδηγήσει σε διάφορα προβλήματα υγείας, όπως πεπτικά προβλήματα, μυκητιάσεις και συμπίεση...

Ο μύκητας Aspergillus fumigatus βρίσκεται στην κορυφή του καταλόγου των ανησυχητικών μυκητιασικών ασθενειών του Παγκόσμιου Οργανισμού Υγείας.
Υπάρχει τεράστιο έλλειμμα σε φάρμακα αλλά και διαγνωστικά εργαλεία, αναφέρει σε νέα έκθεσή του.

Η αυξημένη εφίδρωση και η αφυδάτωση που συχνά την συνοδεύει ανοίγουν τον δρόμο στην ανάπτυξη μυκήτων, μικροβίων και λίθων...

Κνησμός, μορφώματα και πόνος στην ευαίσθητη περιοχή είναι μερικά από τα συνηθισμένα συμπτώματα που ανησυχούν τις γυναίκες

Ο δρ Δημήτρης Κοντογιάννης, καθηγητής Ιατρικής του Πανεπιστημίου του Τέξας και διευθυντής του Κέντρου Ερευνών Άντερσον για τον Καρκίνο,...

Ένας Έλληνας επιστήμονας, ο Δημήτρης Κοντογιάννης, καθηγητής ιατρικής του Πανεπιστημίου του Τέξας και του Κέντρου Ερευνών Άντερσον για τον...

Οι θερινοί μήνες είναι η κατ’ εξοχήν εποχή των εξανθημάτων, αφού το δέρμα είναι πιο εκτεθειμένο στα στοιχεία της...

Οι πληροφορίες του προϊόντος Noxafil επικαιροποιούνται προκειμένου να ενισχυθούν οι υπάρχουσες προειδοποιήσεις σχετικά με το ότι οι δυο μορφές...

Τα νύχια αποτελούνται από κεράτινες στιβάδες οι οποίες για γενετικούς λόγους είναι σε άλλους ανθρώπους πιο λεπτές οπότε τα...